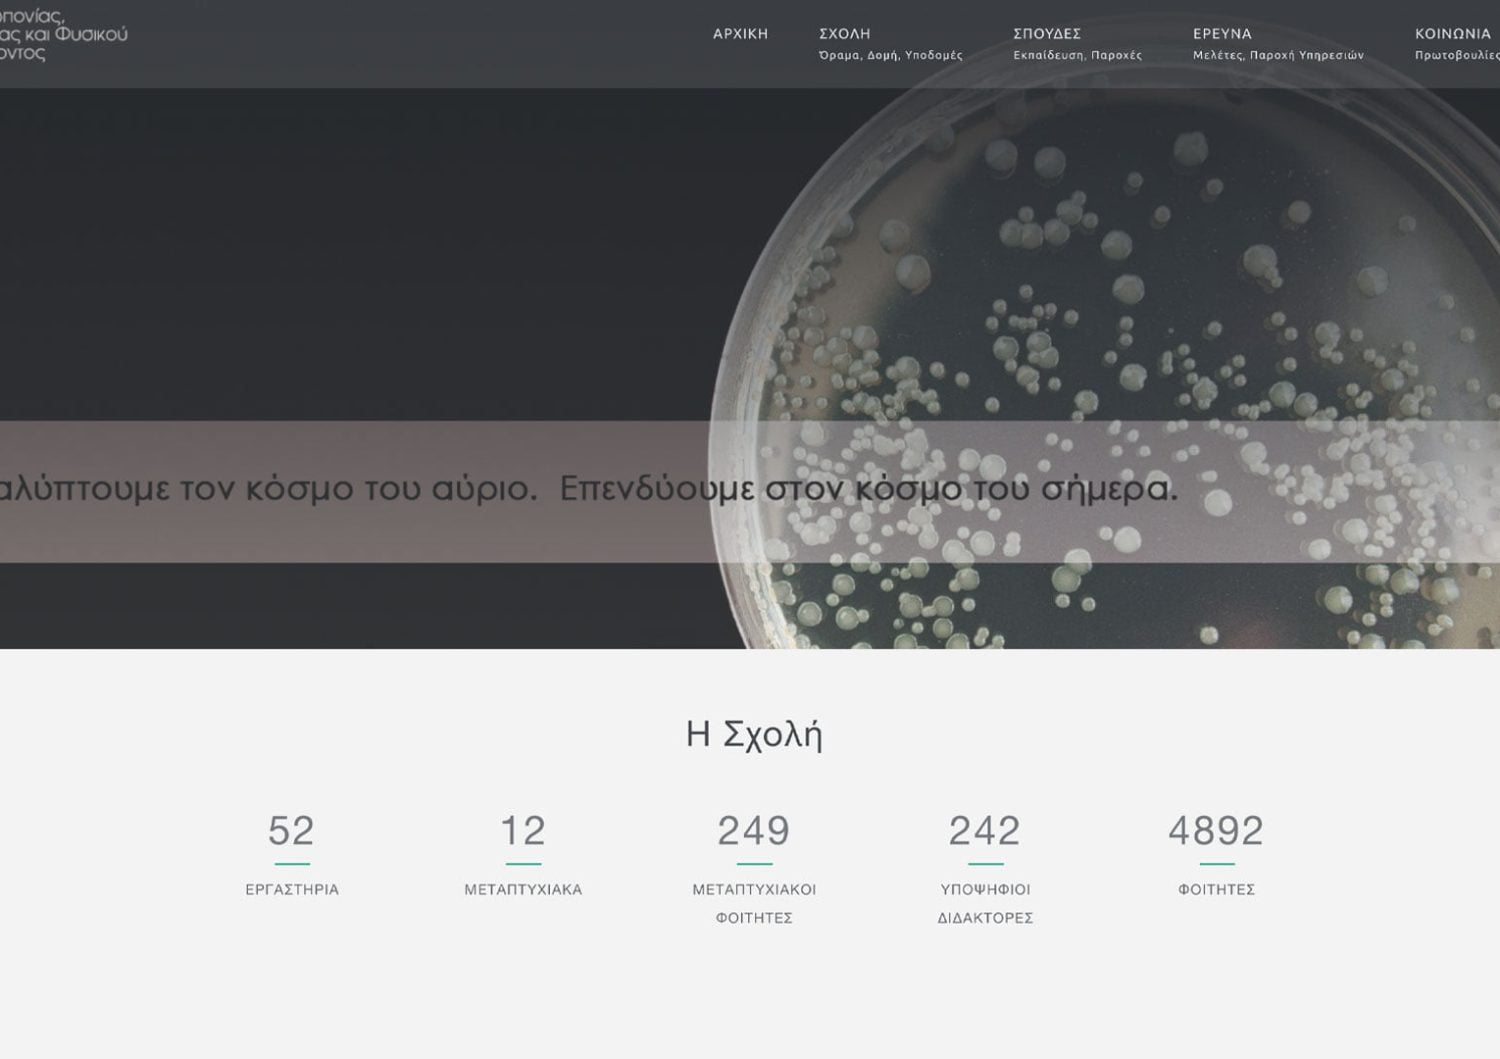
Υπηρεσίες 24 Κατασκευή Ιστοσελίδας - ΑΠΘ Σχολή Γεωπονίας Δασολογίας και Φυσικού Περιβάλλοντος -agrofor.auth.gr

— Υπηρεσίες που παρέχει η EASYDOT CREATIVE
Υπηρεσίες για μικρές οικογενειακές επιχειρήσεις αλλά και μεγάλες πολυεθνικές.
Ασχολούμαστε με την σχεδίαση, ανάπτυξη και κατασκευή ιστοσελίδων, κατασκευή eshop, το Digital Marketing αλλά και οτιδήποτε μπορεί να χρειαστείτε εσείς ή η επιχείρηση σας στον τομέα του διαδικτύου.
ΚΑΤΑΣΚΕΥΗ ΙΣΤΟΣΕΛΙΔΑΣ
Στην EASYDOT CREATIVE είμαστε ειδικοί στην κατασκευή ιστοσελίδων, είτε χρησιμοποιώντας το WordPress είτε δημιουργώντας προσαρμοσμένες λύσεις. Με γνώση και εμπειρία στον τομέα, προσφέρουμε φιλικές και επαγγελματικές ιστοσελίδες που ανταποκρίνονται στις ανάγκες σας. Επικοινωνήστε μαζί μας για να ξεκινήσουμε τη δική σας ιστοσελίδα σήμερα.
Ενδιαφέρομαι για Κατασκευή ΙστοσελίδαςΚΑΤΑΣΚΕΥΗ ESHOP
Η κατασκευή eshop είναι ο καλύτερος τρόπος για να αυξήσετε τις πωλήσεις της επιχείρησης σας. Από ένα μικρό eshop που λειτουργεί τοπικά μέχρι μεγάλες πλατφόρμες διαχείρισης αποθήκης, δημιουργούμε το ιδανικό ηλεκτρονικό κατάστημα για εσάς. Είτε είστε μικρή οικογενειακή επιχείρηση είτε μεγάλη εταιρεία, θα δημιουργήσουμε το eshop που θα ανταποκρίνεται στις ανάγκες και τις προσδοκίες σας.
Ενδιαφέρομαι για Κατασκευή eshopΑΝΑΚΑΤΑΣΚΕΥΗ ΙΣΤΟΣΕΛΙΔΑΣ
Ανακατασκευάζουμε την ιστοσελίδα σας, διορθώνουμε τα λάθη της και την αναβαθμίζουμε σε τεχνολογίες σύγχρονες. Ειδικότητα μας η ανακατασκευή της παλιάς ιστοσελίδας σας ή και του eshop σας σε μια ιστοσελίδα νέα, μοντέρνα και φιλική προς το χρήστη. Επικοινωνήστε μαζί μας για να επαναφέρουμε την παλιά σας ιστοσελίδα στο σήμερα!
Ενδιαφέρομαι για ανακατασκευή ιστοσελίδωνΠΛΑΤΦΟΡΜΑ eLearning
Έχετε φροντιστήριο ή είστε εκπαιδευτής και θέλετε να παραδίδετε online μαθήματα; Ελάτε να κατασκευάσουμε την e-learning πλατφόρμα σας με την υπογραφή και την αξιοπιστία της EASYDOT CREATIVE.
Ενδιαφέρομαι για πλατφόρμα eLearningΤΕΧΝΙΚΗ ΥΠΟΣΤΗΡΙΞΗ
Σας παρέχουμε ολοκληρωμένη λύση στα προβλήματα που ενδέχεται να αντιμετωπίζετε με την ιστοσελίδα σας ή το eshop σας. Άμεση τεχνική υποστήριξη ιστοσελίδας ή και ηλεκτρονικών καταστημάτων 24 ώρες τη μέρα, 7 ημέρες την εβδομάδα, 365 ημέρες το χρόνο είμαστε εδώ για να σας βοηθάμε!
Χρειάζομαι Τεχνική υποστήριξη ιστοσελίδωνΦΙΛΟΞΕΝΙΑ
Η φιλοξενία που παρέχουμε σε δικούς μας server στην Γερμανία είναι από τους ταχύτερους και πιο αξιόπιστους στην Ευρώπη!
Συνεργασία με τη RUNNER.GRSEO – AdWords
Κάνουμε τη σελίδα σας φιλική για τις μηχανές αναζήτησης (SEO friendly) και δημιουργούμε τις καμπάνιες σας στο AdWords με στόχο την αύξηση επισκεψιμότητας ιστοσελίδων αλλά και μεγιστοποίηση των πωλήσεων του eshop σας.
Ενδιαφέρομαι για Digital Marketing & Social Media MarketingΥΛΟΠΟΙΗΣΗ PROJECT
Ανάμεσα στις υπηρεσίες που παρέχουμε είναι και η δική σας ιδέα! Έχετε μία ιδέα και θέλετε να την υλοποιήσετε αλλά δεν βρίσκετε τον κατάλληλο συνεργάτη; Είμαστε εδώ να την ακούσουμε και να την υλοποιήσουμε μαζί!
Πείτε μας τι σκέφτεστε!SOCIAL MEDIA STRATEGY
Η στρατηγική σας μέσα από τα δίκτυα κοινωνικής δικτύωσης, καθορίζεται από εμάς για εσάς, αφού γνωρίσουμε πρώτα εσάς και τις ανάγκες της επιχείρησης σας, δημιουργούμε το κατάλληλο περιεχόμενο για τα Social Media.
Ενδιαφέρομαι για Social Media Strategy